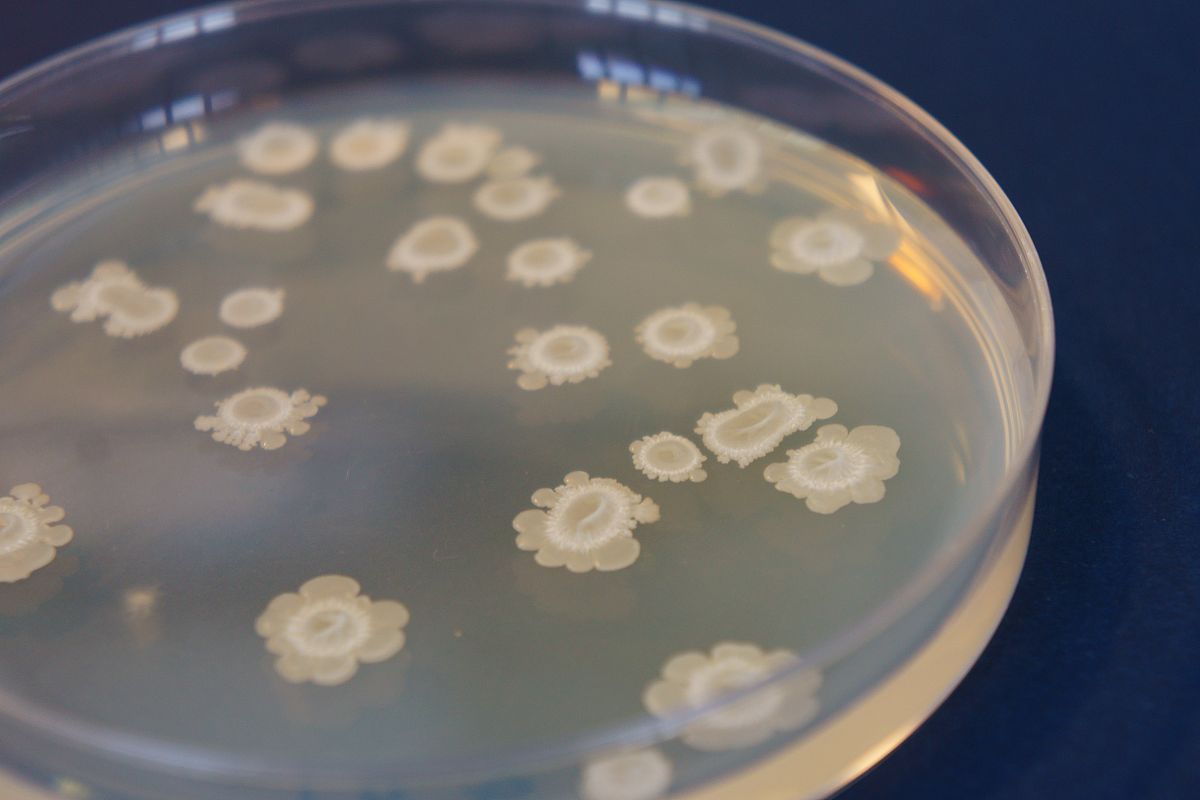
CFU−mL用中文解释一下

CFU−mL用中文解释一下
CFU−mL是一种测量单位,用于表示在一毫升(mL)液体中的细菌或其他微生物的数量。CFU代表“菌落形成单位”(Colony Forming Unit),它是指在培养基上生长形成一个可见的菌落所需的单个细胞或孢子的数量。因此,CFU−mL表示每毫升液体中的菌落形成单位的数量。这个单位通常用于评估液体样品中的微生物含量,比如食品和饮用水的微生物质量控制。
原文地址: http://www.cveoy.top/t/topic/jfOl 著作权归作者所有。请勿转载和采集!